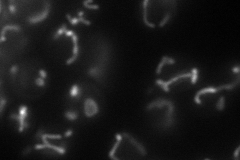
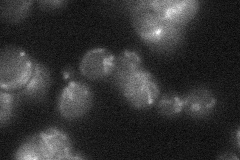

View description
Mitochondrial inner membrane protein required for delivery of copper to the Cox1p subunit of cytochrome c oxidase; association with mitochondrial ribosomes suggests that copper delivery may occur during translation of Cox1p
Localization:
Intensity:
Fold change:
Significance:
-
C’ GFP library in SD

below threshold16.01 -
N' NOP1pr-GFP in SD
mitochondria62.6661 -
N' TEF2pr-mCherry in SD

missing0 -
N' NATIVEpr-GFP in SD
mitochondria22.1052 -
N' TEF2pr-VC and Cyto-VN in SD

#N/A0 -
C’ GFP library in SD+DTT

cytosol15.610.97No -
C’ GFP library in SD+H2O2

cytosol15.530.96No -
C’ GFP library in Starvation Media

cytosol16.241.01No -
C’ GFP library on the background of Pup2-DaMP

below threshold -
C’ GFP library on the background of CCT mutant

below threshold14.79070.923211No
